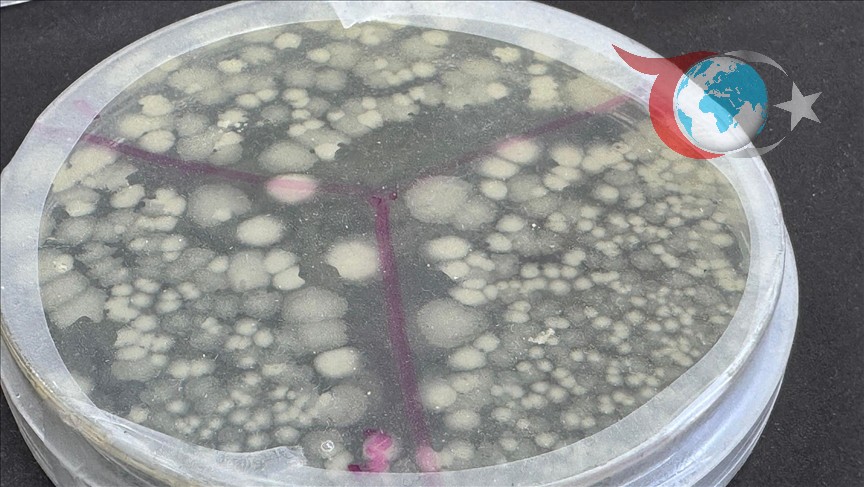

Күн тәртібі
Ағымдағы жаңалықтар мен дамулар
Süper Lig
#
Takım
O
G
B
M
P
1
Galatasaray
26
20
4
2
64
2
Fenerbahçe
27
17
9
1
60
3
Trabzonspor
27
18
6
3
60
4
Beşiktaş
27
15
7
5
52
5
Rams Başakşehir
27
12
7
8
43
Malatya Namaz Vakitleri
26 Mart 2026 - Perşembe
İmsak
04:52
Güneş
06:15
Öğle
12:38
İkindi
16:07
Akşam
18:51
Yatsı
20:07
Döviz & Altın
Çeyrek Altın
+0,03%
₺10.281,11
EUR Euro
-0,03%
₺51,3441
GBP İngiliz Sterlini
-0,24%
₺59,3480
Gram Altın
+0,04%
₺6.285,23
Tam Altın
+0,03%
₺40.999,44
USD Amerikan Doları
+0,01%
₺44,3531
Yarım Altın
+0,03%
₺20.593,47
Malatya Nöbetçi Eczaneler
TREND PARK ECZANESİ
Çilesiz Mahallesi, Abdurrahman Gazi Caddesi No:4/F Yeşilyurt / Malatya
PÜTÜRGE ECZANESİ
Taşbaşı Mahallesi, Hükümet Caddesi No:36, Pütürge (Pötürge) / Malatya
FURKAN ECZANESİ
İstiklal Mahallesi, Cumhuriyet Meydanı No:16/C Kuluncak / Malatya
LİMON ECZANESİ
Özalper Mahallesi, Gülümser Caddesi No:83/A Yeşilyurt / Malatya
BURCU KİĞILI ECZANESİ
Hamidiye Mahallesi, İnönü Caddesi, No:19/A Merkez / Malatya